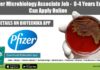
Pfizer Microbiology Associate Job – 0-4 Years Exp Can Apply Online Pfizer Microbiology Job 2022

Study Demonstrates How Fructose Plays A More Damaging Role Than Glucose In Fatty Liver...
Glucose In Fatty Liver Disease or Fructose?
Glucose In Fatty Liver Disease: There is a worldwide epidemic of obesity, type 2 diabetes, and metabolic syndrome....
PhD Admission – IISER Tirupati January 2018 Session
PhD Admission - IISER Tirupati January 2018 Session
The PhD programme at IISER Tirupati was initiated in August 2017. We invite applications from prospective candidates...
PhD Admissions – Saha Institute of Nuclear Physics January 2018 Session
PhD Admissions - Saha Institute of Nuclear Physics January 2018 Session
Candidates with NET-JRF (not Lectureship) qualification are invited to join the Ph. D. programme...
Research Fellowships – Swiss Government Excellence Scholarships 2018
Research Fellowships - Swiss Government Excellence Scholarships 2018
Academic year: 2018-2019
Country: India
Opening of the call: 01 August 2017
Submission deadline: 12 November 2017
Scholarship : Swiss Government Excellence...
Biotecnika Times – Newsletter 11.10.2017
Govt Research Job @ Bureau of Police Research & Development | Scientist Posts Vacant
The Bureau of Police Research & Development is proposed to fill...
CEO Speak: Its BioTecNika’s 11th Birthday & we have a Surprise Gift for you
CEO : Its BioTecNika's 11th Birthday & we have a Surprise Gift for you
Wednesday, 11th October 2006, Time was approximately 5 PM IST when the...
PolarityTE Announces U.S. FDA Registration Of Its Skin-Regeneration Platform
Polarity Announces U.S FDA Registration Of Skin-Regeneration Platform
PolarityTE, the regeneration medicine outfit, has now announced the Federal registration of lead candidate SkinTE, an autologous construct...
FDA Approves Alere’s 15-minute Influenza Diagnostic Test
FDA Approves Alere's 15-minute Influenza Diagnostic Test
The Alere™ i Influenza A & B test is now all set to revolutionize rapid flu testing by providing highly accurate,...
Mosquito Gut Flora Could Hold Key To Cutting Malaria Spread
Mosquito Gut Flora Could Hold Key To Cutting Malaria Spread
Malaria persistently evades our best efforts to eliminate it. The huge burden of malaria in...
Universal Flu Vaccine- World’s First Widespread Human Testing of a Flu Vaccine Commences
World’s First Widespread Human Testing of a Flu Vaccine Commences
Current flu vaccines have to be changed each year to match strains of virus circulating...
Study Exonerates “Gatekeeper” Neurotransmitters In Pain Transmission
Study Exonerates “Gatekeeper” Neurotransmitters In Pain Transmission
During the 1960s, neuroscientists Ronald Melzack and Patrick Wall proposed an influential new theory of pain. At the...
Eli Lilly Leadership Reshuffle- Names New CFO, Replaces Head Of R&D
Eli Lilly Leadership Reshuffle- Names New CFO, Replaces Head Of R&D
Indiana-based global pharmaceutical company, Eli Lilly, has now announced important leadership changes. The firm...
PhD Admissions – University of Hyderabad January 2018 Session
PhD Admissions - University of Hyderabad January 2018 Session
UNIVERSITY OF HYDERABAD
(A Central University Established by an Act of parliament)
PhD Admissions January 2018 Session
University of...
Postdoctoral Scholarships 2018 Under Swiss Government Excellence Scholarships
Postdoctoral Scholarships 2018 Under Swiss Government Excellence Scholarships
Swiss Government Excellence Scholarships
Postdoctoral Scholarships
Academic year: 2018-2019
Country: India
Opening of the call: 01 August 2017
Submission deadline: 12 November...
Swiss Government Excellence PhD Scholarships 2018-19 For Indian Students
Swiss Government Excellence PhD Scholarships 2018-19 For Indian Students
Swiss Government Excellence Scholarships
PhD Scholarships
Academic year: 2018-2019
Country: India
Opening of the call: 01 August 2017
Submission deadline: 12...